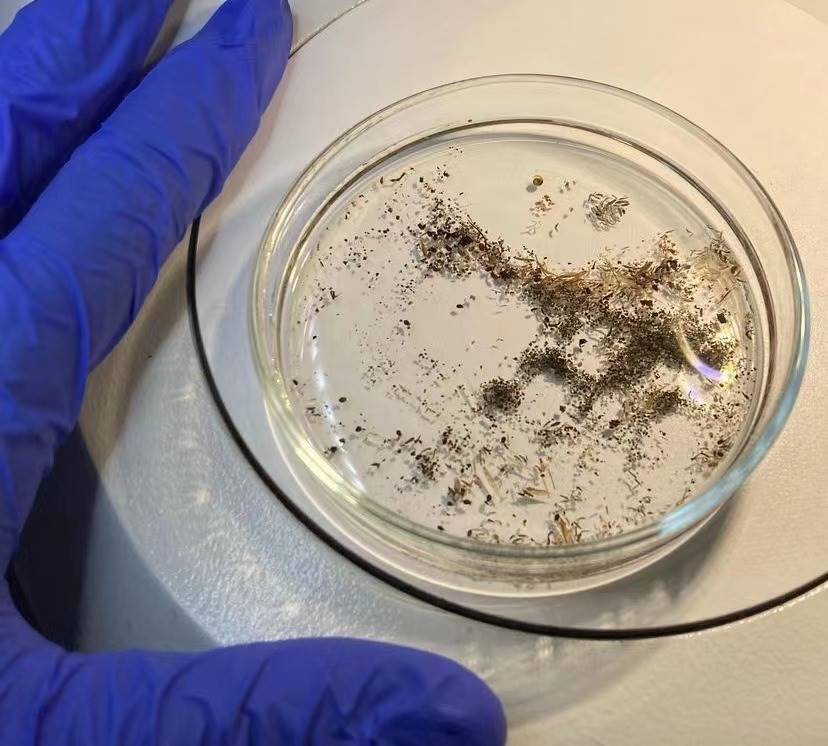

在日常生活中,螨蟲是一種非常常見的寄生在皮膚,紡織品上的生物。它們會給我們帶來很多問題,例如引起皮膚瘙癢、鼻炎、哮喘等。
因此,如何有效地去除螨蟲是我們需要關注的問題。

我們總是以為,把床單被套洗得干干凈凈,然后晾曬在陽光下,就能徹底殺死潛藏在其中的螨蟲。
但實際上,暴曬并不能有效地去除所有的螨蟲。這是因為螨蟲的生命力非常頑強,它們可以在高溫下存活一段時間,而且有些螨蟲還會躲在物品的縫隙中躲避陽光的照射。
然而,你可能不知道的是,螨蟲其實最怕的并不是「暴曬」。
那麼,究竟是什麼讓這些討厭的小東西聞風喪膽呢?
首先,我們要明白螨蟲的習性。
螨蟲是一種喜歡潮濕、陰暗環境的微小生物,它們以人體或動物脫落的皮膚細胞和油脂皮屑為食。
因此,我們的床上用品、地毯、沙發和毛絨玩具,養的寵物貓狗等都是螨蟲的最愛。
而且螨蟲的繁殖速度非常快,這也就意味著,如果你的臥室中有螨蟲,用不了多久,它們就會在整個家大量繁殖,讓你的臥室和客廳沙發地毯等場所變得不再舒適。

螨蟲最怕的是什麼呢?
經過科學家的研究發現,螨蟲最怕的其實是干燥和高溫。
這是因為,螨蟲的身體由大量水份組成,如果環境過于干燥,它們就無法生存。而高溫則會直接殺死螨蟲。
因此,我們完全不需要通過暴曬床單被套來殺死螨蟲,只需要保持臥室的干燥和清潔,就能有效防止螨蟲的出現。
如何在臥室中放置一些「神奇物品」,讓螨蟲無處藏身。
除濕器:
除濕器是臥室中必不可少的電器之一。
它可以有效地降低臥室的濕度,防止螨蟲的滋生。
在選擇除濕器時,我們應該選擇容量大、效果好的產品,以確保臥室的濕度始終保持在適宜的范圍內。

空氣凈化器:
空氣凈化器不僅可以清除臥室中的塵埃和細菌,還可以通過濾網過濾掉空氣中的螨蟲及其糞便。因此,使用空氣凈化器也是防止螨蟲的有效方法。
紫外線除螨儀:
紫外線除螨儀是利用紫外線殺死螨蟲的一種設備。
它可以在短時間內殺死大量的螨蟲,效果非常好。但是,在使用時也要注意,避免直接對人體照射,以免造成傷害。

薰衣草精油:
薰衣草精油具有很好的殺菌和驅蟲效果,可以有效地殺死螨蟲。
我們可以將薰衣草精油滴在棉球上,然后放在床鋪四周,或者直接滴在床上用品上,讓螨蟲遠離我們。
香茅精油:
香茅草精油是一種天然的植物提取物,具有驅蚊、抗菌、消炎等作用。將它放在臥室里,可以有效地去除螨蟲和減少過敏原。
我們可以將香茅草精油滴在紙巾上,然后輕輕擦拭床上、沙發上、地毯等容易滋生螨蟲的地方。
樟腦丸:
樟腦丸是一種常見的驅蟲物品,它的香味可以讓螨蟲無法忍受。我們可以將樟腦丸放在床下或者衣柜中,讓螨蟲遠離我們。

除此以外,我們還可以采取以下措施預防螨蟲的滋生:
1.保持室內通風干燥,減少濕度和溫度適宜的條件,以防止螨蟲滋生。
2.經常清洗床上用品、沙發套、地毯等容易滋生螨蟲的物品。
3.在存放衣物、書籍等物品時,可以使用吸塵器或者樟腦丸等物品來防止螨蟲滋生。
4.在飲食方面,可以多吃一些清熱解毒的食物,例如綠豆湯、金銀花茶等,有助于清除體內毒素和預防螨蟲滋生。

綜上所訴,我們可以了解到暴曬并不能有效地去除所有的螨蟲,可以采取一些預防措施來防止螨蟲的滋生。
在日常生活中,我們應該注意保持室內衛生和通風干燥,經常清洗容易滋生螨蟲的物品,以及合理飲食和適當鍛煉等措施來預防螨蟲的滋生和保持身體健康。
以上就是我為大家介紹的防止螨蟲的方法,希望對大家有所幫助。

版權所有,禁止轉載。 違者必究法律責任。